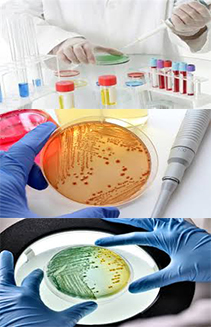
diapo-bacteriologie-right labo A.boukhatmi

Les étapes de biologie médicale à notre laboratoire d'Analyses Médicales d'Oran

Prélèvement sanguin

Prélèvement d'urine

Prélèvement de salive

Prélèvement de peau

Etape d'analyse type 1

Etape d'analyse type 2

Etape d'analyse type 3

Etape d'analyse type 4

Etape d'analyse type 5

Etape d'analyse type 6

Résultats
 Au laboratoire :
Au laboratoire :
 Pour un prélèvement sanguin :
Pour un prélèvement sanguin :
Afin de vous éviter toute attente inutile, prenez rendez-vous en ligne sur notre site : www.monlabo-drboukhatmi-oran.net ou téléphonez au laboratoire afin de prendre un rendez-vous.
Présentez vous au laboratoire avec votre ordonnance et muni de votre carte vitale ou de votre attestation carte CHIFA. Les examens suivants sont à effectuer après une période de jeune strict de 12 heures:
![]() Apo lipoprotéines, Bilan lipidique, Cholestérol total, HDL et LDL, Triglycérides
Apo lipoprotéines, Bilan lipidique, Cholestérol total, HDL et LDL, Triglycérides
![]() Electrophorèses
Electrophorèses
![]() Glucose (glycémie)
Glucose (glycémie)
![]() Test respiratoire à l’urée
Test respiratoire à l’urée
 Vous souhaitez effectuer un examen bactériologique, un examen d'urine...
Vous souhaitez effectuer un examen bactériologique, un examen d'urine...
Prenez un rendez-vous en ligne en prenant soin de respecter les conditions suivantes :
Les résultats :
Les résultats :
Les délais de rendu de résultat sont consultables sur la liste des analyses Vous pouvez consulter vos résultats sur internet à condition d’avoir signé la décharge que vous a donné votre préleveur et de lui avoir communiqué votre numéro de téléphone portable. Vous serez prévenu par un SMS de la mise à disposition de vos résultats sur le site du laboratoire. Votre identifiant de connection vous sera communiqué par ce SMS. À partir de ce moment ceux-ci y seront présents sur notre site pendant de 3 jours. Au format PDF ceux-ci peuvent être imprimés directement à votre domicile. Les résultats disponibles par SMS ne sont pas disponibles par écrit.
 Confidentialité :
Confidentialité :
Les données informatiques concernant les patients sont soumies au secret médical et sont strictement confidentielles.

 Bibliographie :
Bibliographie :
Vous pouvez trouver toutes les informations que vous désirez sur les analyses et leurs interprétations en cliquant sur le lien ci-après qui vous redirigera sur un site vérifié par la Société Française de Biologie Clinique: Dictionnaire des analyses médicales
 Manuel de Prélèvements :
Manuel de Prélèvements :
Toutes les informations nécessaires aux prélèvements sont regroupées dans ce manuel des "Hôpitaux Universitaires de Strasbourg", actions sensiblement tout proches pratiquées par notre laboratoire d'analyses médicales d'Oran... Docteur A.Boukhatmi, que vous pouvez consulter avant de vous rendre au laboratoire. Manuel de prélèvement

 Les causes de la constipation, des ballonnements et des troubles digestifs
Les causes de la constipation, des ballonnements et des troubles digestifs
Éviter cet aliment commun – il peut causer de la constipation, des ballonnements et des troubles digestifs Voir la vidéo
Copyright © 2017 Laboratoire d'Analyses Médicales d'Oran - Clinique Dr Ali Boukhatmi
